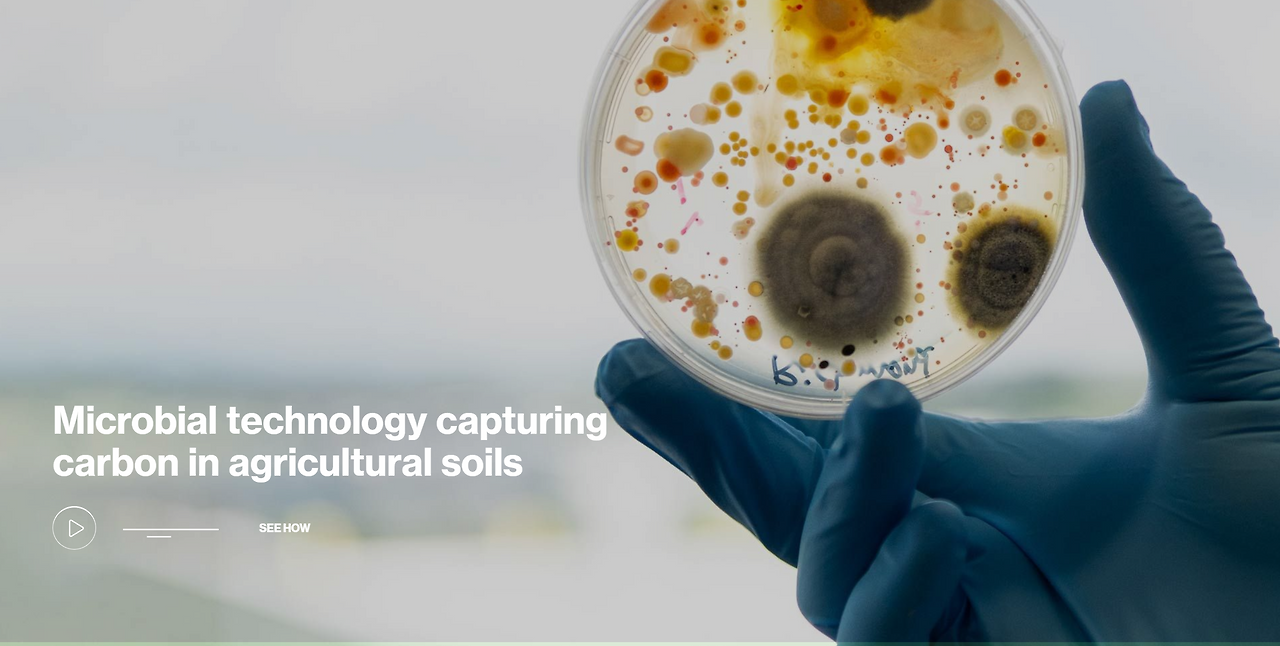
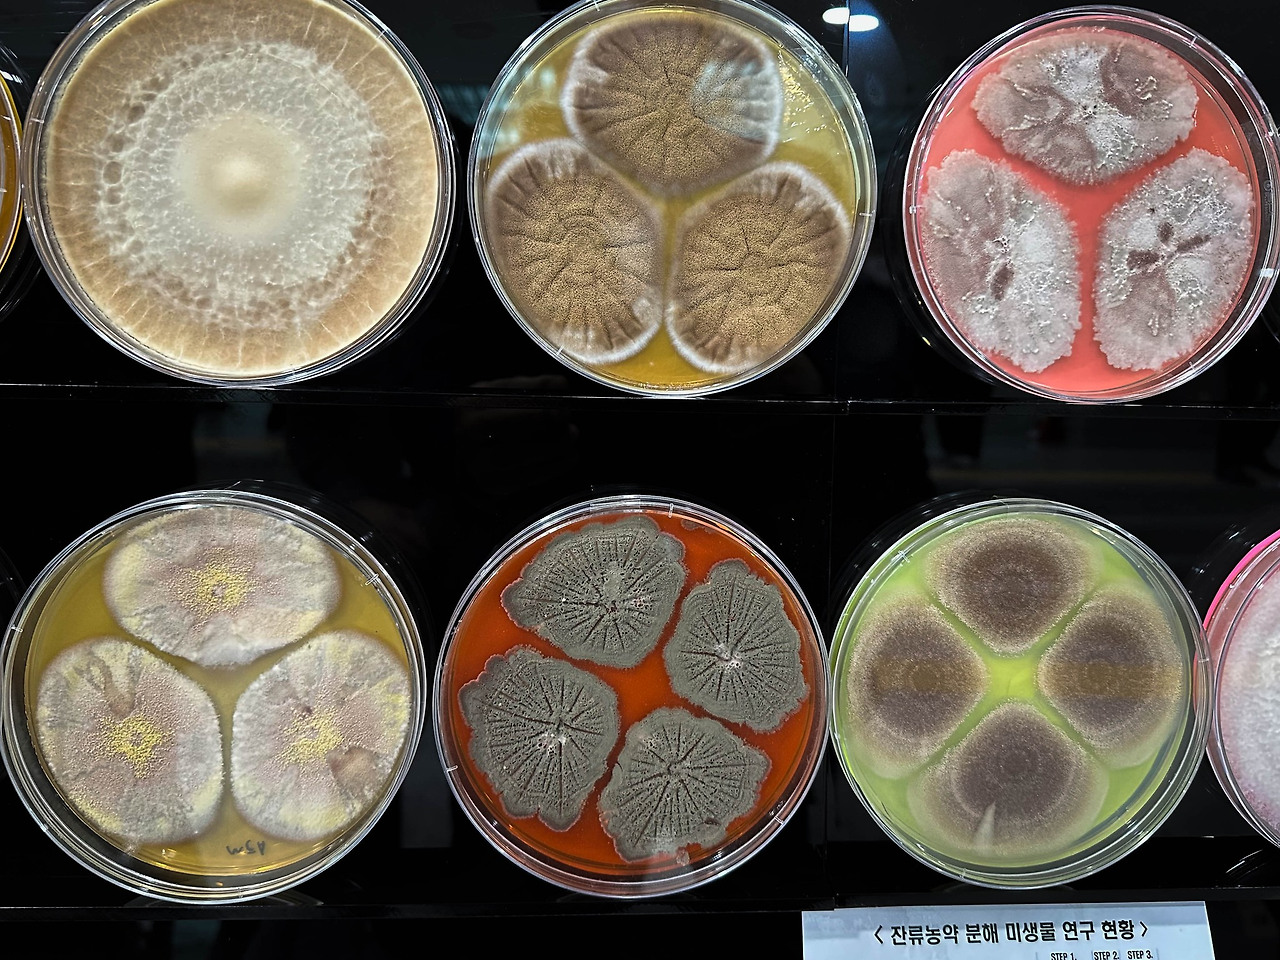

토양 탄소격리를 위한 획기적인 접근 방법
종자에 미생물을 코팅하는 기술을 적용
토양탄소격리를 전문으로 하는 스타트업인 Loam Bio 사는 73백만 달러의 시리즈 B 투자를 유치했다. 흔한 뉴스 중 하나일 수도 있다. 토양탄소격리를 추구하는 스타트업이야 많았으니. 솔직히 지금까지 무경운(No-till)에 의한 토양탄소격리 방법에 대한 신뢰는 크지 않았다. 그래서 뭐 이렇게까지 크게 투자를 하나라면서 뉴스를 살펴봤다.
아직 세상에는 놀랄만한 아이디어가 여전히 남아 있다.
너무 기발했다.
사실 기발했다기보다는 내가 무관심했다. 관련된 기작은 이미 오래전부터 밝혀져 있었다. 그런데 우리는 그걸 탄소중립, 즉 토양탄소격리와 연결시킬 수 있다는 생각을 하지는 못했다. 상상력의 부재이고, 서로 다른 필드 간 협업의 부재이다. 더 나아가서는 우리나라 토양학을 포함한 농학 전반의 쇠락과도 맞물려 있다.
다시 주제에 집중하면... 먼저 이 주제를 이해하려면 미세응집체(microaggregate)라는 것에 대한 이해가 필요하다. 토양 속에서 유기물은 물리적인 토양입자와 따로 떨어져 있다고 생각하지만 미세한 탄소입자의 경우에는 토양 입자와 물리적인 응집(aggrigation)을 이루고 있다.
* Microaggregate : 유기물-미네랄의 상호작용의 결과로 미세응집체(microaggregate)가 형성되는데, 이 물질은 장기적인 탄소 축적에 기여한다.
토양에 존재하는 탄소는 여러 형태가 있다. 대부분의 탄소는 빠르게 분해된다. 만약 그렇지 않았다면 흙은 유기물로 뒤덮여 있었을 것이다. 반면에 미세한 입자상 탄소 또는 난분해성 탄소는 토양에 훨씬 더 안정적으로 존재한다. 전통 토양학에서는 이를 부식물질(humus)라고 불렀다. 부식은 토양입자를 결합시켜 작은 입단을 만드는데, 이게 토양의 통기성과 물 빠짐을 좋게 한다. 토양학에서는 중요하게 다룬다. 유기물을 토양에 주는 이유도 이 부식물질을 늘리기 위한 노력의 하나이다.
'CarbonBuilder'의 작동방식
Loam Bio사"Carbon Builder"의 작동원리는 다음과 같다. 먼저 곡물종자를 곰팡이 액으로 코팅을 한다. 파종을 할 때 종자만 흙속에 들어가는 게 아니라 곰팡이까지 같이 들어간다. 일종의 미생물 처리제라고 볼 수 있다. 씨앗이 발아하여 식물이 자라 광합성을 하면 잎에서 고정된 탄수화물을 뿌리로 내려보낸다. 이 뿌리 배출물(exudate)을 곰팡이가 이용하면서 부식성 물질을 배출하고, 이 물질이 토양의 미세응집체와 결합하여 탄소를 불용화시킨다. 사실 이 부분은 비전문가가 소개를 하다 보니 부정확하게 기술되어 있지만 대충 이렇게 이해된다.
 Loam Bio 사의 홈페이지에서 가져
Loam Bio 사의 홈페이지에서 가져만약 곰팡이를 코팅한 곡물종자가 광범위하게 사용된다면 토양의 입단 형성에 기여함으로써 토양을 비옥하게 하는 것은 물론 탄소격리(carbon sequestration) 효과까지 기대할 수 있다. 만약 세계 농경지 18억 ha에 이러한 접근방법이 적용되면 얼마나 많은 탄소를 격리할 수 있을까? 이렇게 Loam Bio 창업자 들은 묻고 있다. 투자자들은 아마도 여기에 동의한 것일 테고.
농학자로서 나의 입장은?
기발하기도 하면서 역시 의심의 눈초리도 있다. 또 이런 게 있어야 과학자의 기본 자질이기도 하니 이해를 해줘야 하는 부분이기도 하다. 미심쩍은 측면은 계속 자료를 찾아보면서 이해도를 높여나갈 생각이다.
어쨌든 놀랍게도 Loam Bio사는 2개국 29개 사이트에서 6,000개의 개별 시험구에 파종을 하면서 검증을 했다. 보리 재배에서는 헥타르 당 3~5 토양탄소 단위를, 다른 토양관리법 대비 3~6배 정도 탄소를 늘릴 수 있었다고 한다. (이 부분 역시 기사에서는 모호하게 기술되어 있다.) 창업자들은 이 방식의 토양탄소격리가 무경운(no-till) 같은 탄소격리 방법보다 훨씬 안정적이고 농민들도 이행하기 쉽다고 말한다. 이건 당연한 소리이다. 무경운 농법은 그리 쉽지 않다. 그래서 내가 이 방법이 가능성이 없는 건 아니지만 제한적으로 적용될 수밖에 없어서 약간 미심쩍은 입장을 취하고 있다. 반면에 Loam bio사의 방법은 전통적인 토양학자들이 추구하는 이상적인 상황을 만들면서 탄소를 격리한다. 가능하다면 쌍수를 들고 환영할 일이다.
'SecondCrop'의 작동방식
여기서 끝이 나면 좋았겠지만 결코 그렇게 되는 법은 없다. Loam Bio사는 이걸 비즈니스 모델로 연결해야 하는데 그게 SecondCrop이다. 모든 게 그렇지만 농민들이 코팅된 종자를 채택해야 이 사업이 추진될 수 있다. 당연히 가격이 더 비싼 종자를 채택하게 하려면 결국 인센티브가 필요하다. 종자를 판매 하고 토양탄소를 측정하고, 생산성도 측정할 테고, 그렇게 해서 격리된 탄소만큼 농민들에게 혜택을 제공함으로써 이 BM이 계속 작동하게 만든다. 논리구조의 정합성은 뛰어나다.
Accelerating Carbon Farming, Loam Bio 홈페이지에서 인용
Accelerating Carbon Farming, Loam Bio 홈페이지에서 인용경쟁력의 기반은 무엇일까?
결국 이 BM이 작동하기 위한 핵심인자는 종자 코팅에 사용한 곰팡이 균이다. 아마도 단일균일지 아니면 복합균일지는 모르겠지만, 토양뿌리에서 탄수화물의 분비(exudate)를 촉진하고 그걸 응집력이 있는 휴머스성 물질로 바꿔주는 미생물 균주를 어떻게 확보하느냐가 관건이다. 이건 토양조건과 기후대에 따라 달라지기 때문에 다양한 사례연구가 필요하고, 다양한 미생물 인벤토리가 필요하다. 통칭해서 토양 마이크로바이(microbiome) 분석 기술이라고 할 수 있다.
우리나라에서도 이 미생물 연구 부분은 꽤나 강하다. 훌륭한 도구를 많이 만들었을 뿐 아니라 정말 과하게 연구 역량도 뛰어나다. 농촌진흥청 씨앗은행(seed valut)에는 종자만 있는 게 아니라 미생물은행(KACC) 함께 있다. 심지어 요청을 하면 균주도 분양을 해준다.
국립농업과학원 농업미생물과에서 전시한 곰팡이 아트 사진
국립농업과학원 농업미생물과에서 전시한 곰팡이 아트 사진그런데 우리는 왜 이런 생각을 못했을까? 그런 생각을 해보는데, 우리는 못하는 게 아니라 이렇게 해야 한다는 걸 잘 생각을 못하는 듯하다. 기업과 연구소를 둘 다 지켜본 입장에서는 서로가 협력해야 한다는 걸 잘 모르거나 아니면 그 방법을 잘 모르고 있다는 생각도 든다. 서로 간 움직이는 속도와 생각의 깊이가 다르다는 걸 인정하기 전에 먼저 상대를 얕잡아 보는 경향도 더러 있는 듯하다.
한 가지 다행스러운 것은 우리도 시도를 하고 있다는 것이다. 마이크로발란스(Micrbalance)라는 스타트업에서는 토양 마이크로바이옴을 다양하게 활용하는 제품을 개발하고 적용하고 있다. 나 역시 기대가 크다. 물론 이렇게 되도록 누군가 역할을 했을 것이다. 그 결과를 조만간 볼 수 있기를 기대하면서... 우리나라도 미래 바이오산업 분야에 대한 과감한 투자가 일어나길 기대한다.
인용문헌
Loam Bio raises $75m, launches tools to improve soil carbon capture (agfundernews.com)